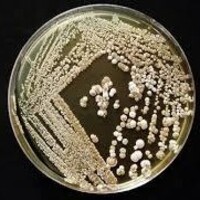
Actinomycetes culture for research work in india

ABCC – Abtri Biorepository Culture Collection
India’s Accessible Microbial Culture Repository for Academia & Industry
India’s Trusted Public Microbial Culture Collection
The Abtri Biorepository Culture Collection (ABCC) is a publicly accessible microbial repository managed by Apex Biotechnology Training and Research Institute (ABTRI), Chennai.
ABCC supports thousands of Indian biotechnology students, colleges, universities, and industries by supplying authenticated microbial cultures at nominal and student-friendly pricing.
Designed for India’s growing research ecosystem, ABCC provides reliable, contamination-free, and well-preserved microbial strains for a wide range of scientific and industrial applications.

Culture Collection Overview
ABCC currently maintains 100+ authenticated microbial cultures, including:
Bacteria (environmental, industrial, research strains)
Fungi (yeasts, filamentous fungi)
Actinomycetes (soil & industrial isolates)
All cultures are ideal for Indian colleges, universities, biotech labs, startups, and industries requiring high-quality, ready-to-use strains.
Typical applications include:
Research projects (UG, PG, PhD)
Industrial R&D
Teaching and practical classes
Bioprocess and fermentation studies
Microbial assay & screening
Strain improvement studies
Why ABCC Is Preferred by Indian Researchers
Key Advantages
- Publicly available within India – no international shipping delays
- Nominal and affordable pricing – ideal for students
- 100+ authenticated strains
- Fast shipping across India
- Quality-controlled preservation
- Easy online request process
- Indian GST billing available for institutions
- ABCC ensures that Indian researchers get quick, dependable, and ethical access to microbial strains without high costs.

Download the ABCC Culture Catalog
Get the Latest List of 100+ Available Strains
Download our complete culture catalogue, including:
Bacterial strains
Fungal strains
Actinomycetes
Strain codes & descriptions
Recommended applications
Pricing information
How to Order Cultures
Step-by-Step Ordering
Download the Culture Catalog
Select the strains you require.Fill Out the Culture Request Form
Provide institutional or personal details.Receive Cultures via Safe Shipment
Cultures are shipped with proper labeling and documentation.
Culture Categories
Available Microbial Types:
Gram-positive bacteria
Gram-negative bacteria
Yeasts
Filamentous fungi
Environmental & soil actinomycetes
Enzyme-producing strains
Research & teaching strains
Indian researchers can request custom sourcing based on availability.
Safety, Compliance & Quality Assurance
ABCC follows Indian and international standards for:
Biosafety handling
Strain authentication
Proper documentation
Cold-chain preservation (where required)
Every culture is delivered safe, pure, and ready to use.
